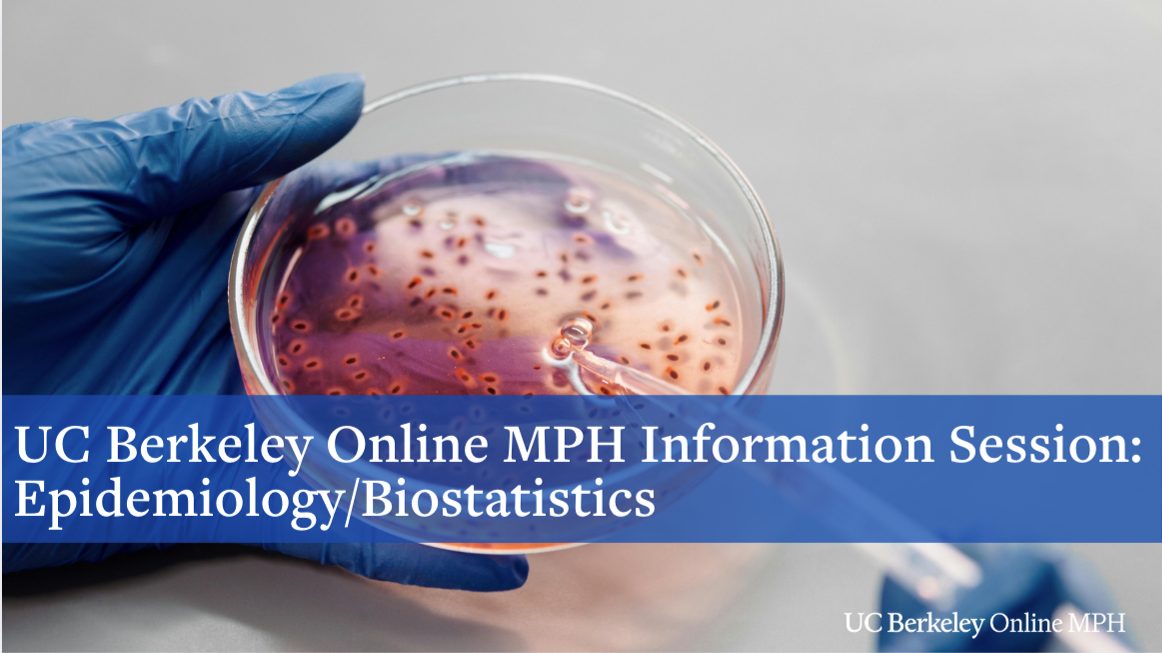

February 4, 2025
@
12:00 pm
–
1:00 pm
This information session aims to provide valuable insights into the program, curriculum, and career opportunities available to prospective students. Whether you are a recent graduate or a seasoned professional looking to advance your skills, this session will offer a comprehensive overview of our program and how it can contribute to your academic and professional growth.